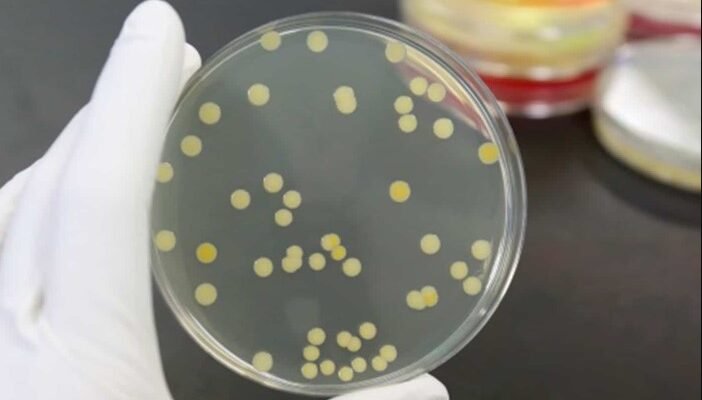
Золотистий стафілокок: Невидимий ворог, який загрожує здоров’ю людини

- Невидимий ворог: що таке золотистий стафілокок і чому він небезпечний
- Що таке золотистий стафілокок: наукове визначення
- Як передається і як проникає в організм
- Коли варто хвилюватися: симптоми зараження
- Найнебезпечніша форма — MRSA
- Як виявити і діагностувати інфекцію
- Що варто знати про лікування та профілактику
- Наслідки і чому не варто ігнорувати
- Золотистий стафілокок — мікроорганізм із подвійним обличчям
Невидимий ворог: що таке золотистий стафілокок і чому він небезпечний
Це бактерія, яка має гарну назву, але зовсім не гарну репутацію. Золотистий стафілокок (Staphylococcus aureus) — це мікроорганізм, часто присутній на нашій шкірі або слизових оболонках, не завдаючи шкоди. Але варто імунітету ослабнути — і ця звичайна бактерія перетворюється на агресивного ворога. Вона здатна викликати все — від незначних гнійників до смертельно небезпечних інфекцій. Її хитрість полягає в здатності швидко адаптуватися, виробляти токсини й формувати стійкість до антибіотиків.
Що таке золотистий стафілокок: наукове визначення
Staphylococcus aureus — це грампозитивна бактерія кулястої форми, яка утворює скупчення, схожі на грона винограду, коли розглядається під мікроскопом. Назва «золотистий» походить від характерного жовтуватого кольору колоній цих бактерій. Вона є умовно-патогенною: у нормі може не шкодити, але за певних умов (травми, ослаблений імунітет, операції) стає причиною серйозних інфекцій.
Ця бактерія володіє надзвичайною стійкістю: вона може виживати на сухих поверхнях, у пилу, на медичних інструментах. Вона також виробляє токсини, які руйнують тканини, уражають органи й навіть блокують імунну відповідь організму.
Як передається і як проникає в організм
Основний шлях передачі — контактний. Стафілокок може потрапити на шкіру з рук, поверхонь, інструментів, одягу. У медичних закладах джерелом інфекції часто є інші пацієнти або персонал. Якщо є порушення цілісності шкіри — подряпини, рани, опіки — бактерії легко проникають всередину. Вони можуть викликати:
- гнійні запалення шкіри (фурункули, карбункули)
- інфекції сечових шляхів
- інфекції після операцій і катетеризацій
- пневмонії, остеомієліти, сепсис
Коли варто хвилюватися: симптоми зараження
Небезпека золотистого стафілокока полягає в тому, що симптоми залежать від того, де саме він активувався. Іноді це лише невелике почервоніння або гнійник, але в інших випадках — це генералізована інфекція, яка вражає кров і внутрішні органи. Серед типових ознак:
- почервоніння, біль і набряк в області ураження
- підвищення температури, озноб
- гнійні виділення з рани
- слабкість, нудота, головний біль
- різке погіршення самопочуття при системному ураженні
Особливо уважними мають бути люди після хірургічних втручань, новонароджені, пацієнти з онкологією, цукровим діабетом, ВІЛ.
Найнебезпечніша форма — MRSA
Однією з найвідоміших форм золотистого стафілокока є MRSA — Methicillin-Resistant Staphylococcus aureus. Це штам, стійкий до метициліну та багатьох інших антибіотиків. Його поява — результат надмірного і безконтрольного використання антибіотиків. Лікування таких інфекцій набагато складніше, адже стандартні препарати не діють.
Як виявити і діагностувати інфекцію
Діагностика передбачає взяття мазків або посівів із вогнища запалення (шкіра, рана, носоглотка, сеча, кров). У лабораторії визначають не лише сам факт наявності стафілокока, а й його чутливість до антибіотиків. Саме це дає змогу лікарю призначити ефективну терапію, а не діяти навмання.
Стафілокок може бути виявлений і випадково — під час профілактичних обстежень, наприклад, у мазках із носа. У таких випадках лікар вирішує, чи потрібно лікування.
Що варто знати про лікування та профілактику
Золотистий стафілокок не завжди потребує лікування, якщо не спричиняє симптомів. Але у разі активної інфекції потрібне комплексне втручання:
- Антибіотикотерапія, підібрана індивідуально за результатами антибіотикограми
- Місцеві антисептики для обробки шкіри або ран
- Дренаж гнійників, якщо є гнійне ураження
- Підтримка імунної системи, включаючи вітаміни та харчування
- Хірургічне втручання, якщо бактерія проникла в глибокі тканини чи органи
Уникнути зараження повністю неможливо, адже стафілокок — це частина середовища. Але можна знизити ризики:
- мити руки з милом, особливо після контакту з поверхнями в публічних місцях
- обробляти навіть дрібні ранки антисептиками
- не використовувати чужі рушники, бритви чи косметику
- слідкувати за чистотою медичних інструментів, особливо у стоматології чи косметології
- зміцнювати імунітет, висипатися, не переохолоджуватися
Наслідки і чому не варто ігнорувати
Інфекція, викликана золотистим стафілококом, може стати загрозою для життя. Сепсис, інфекційний ендокардит, остеомієліт, менінгіт — це не виняткові випадки, а реальні ускладнення. Саме тому важливо не займатися самолікуванням, не ігнорувати симптоми і не відкладати візит до лікаря.
Золотистий стафілокок — мікроорганізм із подвійним обличчям
Це бактерія, з якою ми живемо поруч усе життя. Але вона не пробачає легковажності. У звичайному стані — вона мовчить. У стані активності — діє стрімко і агресивно. Її сила — у здатності адаптуватися, виживати, чинити спротив лікам.
Золотистий стафілокок — це не просто медичний термін. Це виклик для медицини, тест на нашу уважність і відповідальність. Це приклад того, як щось мікроскопічне здатне змінити життя людини. І водночас — нагадування про те, що здоров’я часто залежить від дрібниць.